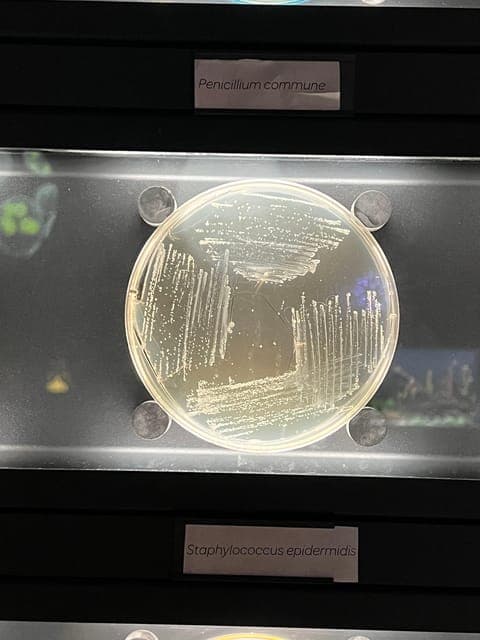
undefined Gallery Image 1

ARTIS-Micropia Microbe Museum Entry Ticket




ARTIS-Micropia is the first and only museum entirely dedicated to microbes. They’re everywhere: in the air, in your gut, on your skin. They make food taste better, keep you healthy, and maintain balance in nature. Microbes are essential!
But this invisible life can only be seen through a microscope. The new exhibition MAGNIFIED – developed in collaboration with Nikon – reveals how microscopes have continuously expanded our view. From the very first lenses to today’s razor-sharp images. Discover how science, technology, and wonder come together in visuals, film, games, and stories.
Step into a world that has always surrounded you – but one you've never truly seen until now.
Want to discover even more? With a combination ticket, you can also visit the ARTIS-Groote Museum, where you’ll explore the profound connections between humans, animals, plants, and microbes. Or head outdoors to ARTIS-Zoo, where nature comes closer than ever before.
Good to Know
- 1 January 10 am - 5 pm
- The only microbe museum in the world
- Daily lab talks in front of the Laboratorium
- Children (age 0-12) can enter for free
- The recommended age for Micropia is 8 years or older
- Open daily from 10 am to 5 pm
- 24 December 9 am - 5 pm
- 25 December 9 am - 5 pm
- 26 December 9 am - 5 pm
- 31 December 9 am - 4 pm
Key Details
- Cancel up to 24 hours in advance for a full refund
- Keep your travel plans flexible — book your spot and pay nothing today.
- Check availability to see starting times
- Dutch, English
Highlights
- Visit the world's only microbe museum in the heart of Amsterdam
- New exhibition: MAGNIFIED – discover the world through the microscope
- Nowhere else will you see so many microbes with your own eyes
- Scan yourself and uncover the microbes living on and inside you
- Free entry for children up to 12 years old
Inclusions
- Admission to ARTIS-Micropia
Exclusions
- Admission to ARTIS Amsterdam Royal Zoo
- Admission to ARTIS-Groote Museum
Description
Meeting Points
- Amsterdam: ARTIS-Micropia Microbe Museum Entry Ticket
Traveler Ratings
See how travelers have rated this attraction. Check out the average rating and read what others have shared about their experiences
4.7 / 5
4.66 out of 5 stars
Based on 495 reviews
Review histogram
5
- 0%
4
- 0%
3
- 0%
2
- 0%
1
- 0%
Traveler Reviews
Discover what other travelers have to say about this attraction. Read their reviews and get insights into their experiences
Traveler Photos
Explore real experiences from other travelers through their photos. See what people have captured during their visit to this attraction




Related Attractions
Explore similar attractions that other travelers have enjoyed. Discover more options to enhance your travel experience

ARTIS-Micropia Microbe Museum Entry TicketARTIS-Micropia Microbe Museum Entry Ticket
Get tickets to the ARTIS-Micropia, the only museum on microbes in the heart of Amsterdam. Discover the most powerful life on earth and learn about the fascinating and invisible world of microbes.
$21
per adult
Van Gogh Museum Admission Ticket & Small-Group TourVan Gogh Museum Admission Ticket & Small-Group Tour
Immerse yourself in the artistry of Vincent van Gogh with a 2
$187
per adult
Amsterdam Cheese and Drinks Boat TourAmsterdam Cheese and Drinks Boat Tour
Enjoy a laid-back, one-hour boat ride aboard a stylish 1930s saloon vessel—the Britannia II—with no more than 12 fellow guests
$25
per adult
Anne Frank Walking Tour Amsterdam Including Jewish Cultural QuarterAnne Frank Walking Tour Amsterdam Including Jewish Cultural Quarter
Discover Amsterdam’s rich Jewish heritage and compelling wartime history with this two-part experience
$73
per adult
The #1 Best Rated Walking Tour in Amsterdam (Tip-based 2,5 hour tour)The #1 Best Rated Walking Tour in Amsterdam (Tip-based 2,5 hour tour)
Experience Amsterdam’s Vibrant Heritage with FreeDam Tours Delve into the compelling history and modern spirit of one of the world’s most liberal cities on a unique tip-based walking tour
$5
per adult
Van Gogh Museum - Exclusive Guided Museum TourVan Gogh Museum - Exclusive Guided Museum Tour
Join an exclusive 2
$186
per adult
Amsterdam Jordaan District Food-Tasting Walking TourAmsterdam Jordaan District Food-Tasting Walking Tour
Begin your culinary adventure in Amsterdam’s Jordaan neighborhood, a former working-class district that has transformed into a bustling gastronomic hub
$110
per adult
Guided Bike Tour of Amsterdam's Highlights and Hidden GemsGuided Bike Tour of Amsterdam's Highlights and Hidden Gems
Take in the very best of Amsterdam—as well as a few tucked-away treasures—on a guided bike tour that’s perfect for short trips or tight schedules
$44
per adult

Food and Culture Walking Tour with TastingsFood and Culture Walking Tour with Tastings
Join a foodie and cultural walking tour in Amsterdam and taste classic Dutch foods while learning about their history. Explore the beautiful city and see some of its historic landmarks.
$93
per adult
Amsterdam Small-Group Food & Culture Tour With TastingAmsterdam Small-Group Food & Culture Tour With Tasting
Amsterdam is paradise for foodies, but knowing where to get started can feel overwhelming
$93
per adult
Amsterdam Canal CruiseAmsterdam Canal Cruise
Cruising down Amsterdam’s iconic canals is one of the most popular activities in the city
$21
per adult
All-Inclusive Amsterdam Canal Cruise with Drinks and Dutch BitesAll-Inclusive Amsterdam Canal Cruise with Drinks and Dutch Bites
Begin your 1
$40
per adult
Amsterdam Morning Canal Cruise with Local Guide + Hot DrinksAmsterdam Morning Canal Cruise with Local Guide + Hot Drinks
This award-winning Amsterdam canal cruise departs in the early morning, before the city comes alive
$50
per adult
Amsterdam Canal Small-Group Cruise with Dutch SnacksAmsterdam Canal Small-Group Cruise with Dutch Snacks
Your intimate Amsterdam canal cruise starts at Keizersgracht, where you board your electric sloop board along with a small group
$70
per adult
Amsterdam Canal Cruise: Small Group in Open-Top BoatAmsterdam Canal Cruise: Small Group in Open-Top Boat
Admire Amsterdam’s top attractions without having to contend with the crowds on land during a cruise of the UNESCO-listed Canal Ring (Grachtengordel)
$34
per adult
Amsterdam Saloon Boat Canal Cruise with Cheese, Drink OptionAmsterdam Saloon Boat Canal Cruise with Cheese, Drink Option
Arrive at a central location in Amsterdam and step aboard a beautifully restored wooden saloon boat for a serene cruise along the city’s UNESCO-listed canals
$33
per adult
Amsterdam Small-Group Canal Cruise with DrinksAmsterdam Small-Group Canal Cruise with Drinks
Take in the beauty and heritage of Amsterdam from the water on a 2-hour cruise along the UNESCO-listed canals and the Amstel River
$46
per adult
Electric Boat Canal CruiseElectric Boat Canal Cruise
Experience Amsterdam’s timeless canals with a contemporary twist on an electric-powered boat
$21
per adult

Queer Contemporary art tour with artist YamunaQueer Contemporary art tour with artist Yamuna
It’s pride season, let’s honour those that pave the way and explore Amsterdams queer art scene with artist Yamuna Forzani!
$353
per adult
Van Gogh Museum Amsterdam Small-Group Tour & Admission TicketVan Gogh Museum Amsterdam Small-Group Tour & Admission Ticket
The Van Gogh Museum in Amsterdam is home to more than 1,000 of the Dutch artist’s paintings, drawings, and letters—but knowing where to find the highlights can be hard
$163
per adult
Private Guided Tour of the Rijksmuseum AmsterdamPrivate Guided Tour of the Rijksmuseum Amsterdam
Meet your guide at the designated spot near the Rijksmuseum and head straight to this world-renowned museum together
$100
per adult
Private Guided Tour: Rijksmuseum and Van Gogh MuseumPrivate Guided Tour: Rijksmuseum and Van Gogh Museum
Skip the long entrance lines and embark on a private, art-focused journey through two of Amsterdam’s most renowned museums: the Rijksmuseum and the Van Gogh Museum
$281
per adult
Van Gogh Museum: Entry TicketVan Gogh Museum: Entry Ticket
Discover the life and art of Vincent van Gogh at the Van Gogh Museum in Amsterdam
$30
per adult
Amsterdam Van Gogh Museum Small-Group Guided TourAmsterdam Van Gogh Museum Small-Group Guided Tour
Explore Amsterdam’s celebrated Van Gogh Museum with an expert guide, delving into the remarkable life and artistic evolution of one of history’s most influential painters
$132
per adult

Streetart Museum STRAAT Entrance TicketStreetart Museum STRAAT Entrance Ticket
Get an entry ticket to STRAAT and visit the world's largest street art museum. Discover an international collection of more than 150 objects, paintings, sculptures, and (some very big) installations.
$23
per adult
Amsterdam Canal Cruise With Live Jazz BandAmsterdam Canal Cruise With Live Jazz Band
Take a break from busy sightseeing with a relaxing cruise along Amsterdam’s canals
$23
per adult
Amsterdam Captain Jacks Signature Cruise - 1,5 hour & Small groupAmsterdam Captain Jacks Signature Cruise - 1,5 hour & Small group
Get a front-row peek at top sights in Amsterdam from the comfort of an electric-powered boat during this luxury canal cruise
$21
per adult

Zaanse Schans 3-Hour Small Group TourZaanse Schans 3-Hour Small Group Tour
Head to Zaanse Schans from Amsterdam to learn about clog making, taste some cheese and step into a working windmill.
$50
per adult
Coqtales Show Ticket: The Hottest Male Show in AmsterdamCoqtales Show Ticket: The Hottest Male Show in Amsterdam
Book ahead and bag your ticket to Coqtales in Amsterdam, the new male strip show in town
$69
per adult
Halloween Walkthrough Experience AmsterdamHalloween Walkthrough Experience Amsterdam
Dare to enter the darkness with The Night Signal: Into the UPside — the most thrilling Halloween Walkthrough Experience in Amsterdam
$24
per adult

Rijksmuseum Guided Tour incl Entrance TicketRijksmuseum Guided Tour incl Entrance Ticket
During a 2-hour guided art tour through the permanent collection of the Rijksmuseum, discover how Rembrandt and Vermeer captured the incredible expansion of the Dutch Golden Age.
$89
per adult

Amsterdam Concert: A. Vivaldi - Four Seasons at BegijnhofAmsterdam Concert: A. Vivaldi - Four Seasons at Begijnhof
Experience an unforgettable evening of classical music in the historic English Reformed Church, located in the heart of Amsterdam’s charming Begijnhof. Vivaldi, Mozart, Beethoven—pure enchantment.
$31
per adult

"Chèri Chèri" - Biggest Drag Show in Europe Entry"Chèri Chèri" - Biggest Drag Show in Europe Entry
Expereince the "Chèri Chèri" drag show at The Harbour Club Theater in Amsterdam with this entry ticket. Enjoy an unforgettable night full of music, dance, comedy, and laughter with your friends.
$82
per adult
Amsterdam Canal Booze Boat - Unlimited Drinks - City CentreAmsterdam Canal Booze Boat - Unlimited Drinks - City Centre
Enjoy an hour and 15 minutes of sightseeing and fun on a private canal cruise with an open Dutch bar offering unlimited beer, wine, and soft drinks
$22
per adult
Amsterdam Electric Boat Canal Cruise with Bar, Live GuideAmsterdam Electric Boat Canal Cruise with Bar, Live Guide
Hop onto a luxury electric boat and glide through Amsterdam’s iconic canals, exploring a host of renowned neighborhoods and landmarks along the way
$20
per adult
The Ultimate Amsterdam Canal Cruise - 2hr - Small Group with Drinks & SnacksThe Ultimate Amsterdam Canal Cruise - 2hr - Small Group with Drinks & Snacks
Cruise Amsterdam’s scenic canals in a fully electric boat, while your hosts give you a glimpse into modern Dutch life
$90
per adult
NEW: 1,5 hour luxury canal cruise starting from RijksmuseumNEW: 1,5 hour luxury canal cruise starting from Rijksmuseum
Get yourself comfortable in our beautifully-designed boat named the MANA
$58
per adult
Brothel Tour with a Former Sex WorkerBrothel Tour with a Former Sex Worker
Discover Amsterdam's best-kept secret and get an exclusive look behind the scenes of Amsterdam's most famous high-end strip and sex club
$26
per adult

Bols Cocktail Experience and Cocktail WorkshopBols Cocktail Experience and Cocktail Workshop
Visit the Bols Cocktail Experience in Amsterdam with a self-guided audio tour, followed by a cocktail-making workshop with a professional bartender. Taste your creations and learn the art of mixology.
$41
per adult
Amsterdam Evening Canal Cruise with Cheese Plates and Open BarAmsterdam Evening Canal Cruise with Cheese Plates and Open Bar
Discover the Dutch capital at its most picturesque and romantic—and enjoy waterfront views of its UNESCO-listed scenery, all lit up after dark—on this evening canalboat cruise
$76
per adult

Brothel Tour with Former Sex WorkerBrothel Tour with Former Sex Worker
Discover the secrets of Amsterdam's famous high-end sex club, Bonton. Explore the club's rooms and listen to the mind-boggling stories of a sex worker on this Tour de BonTon while enjoying a drink.
$27
per adult
Amsterdam Festival of Lights Canal CruiseAmsterdam Festival of Lights Canal Cruise
Enjoy unrivaled views of Amsterdam’s Festival of Lights—which takes place every year from November through January—on a canal cruise that reveals the bests of the installations
$57
per adult
Amsterdam Light Festival Group Cruise With RefreshmentsAmsterdam Light Festival Group Cruise With Refreshments
Get the best views of Amsterdam’s Light Festival while floating along the canals on this group cruise
$32
per adult
Amsterdam Light Festival: Cruise Saloon Boat w/ Hot Drinks optionAmsterdam Light Festival: Cruise Saloon Boat w/ Hot Drinks option
Seeing the highlights of the Amsterdam Light Festival usually involves a lot of walking—and battling with large crowds
$34
per adult
Amsterdam Light Festival Private Canal Cruise with DrinksAmsterdam Light Festival Private Canal Cruise with Drinks
Make your way to central Amsterdam for your cruise departure time
$163
per adult
Keukenhof: Guided Tour + Tulip Farm Visit + Windmill CruiseKeukenhof: Guided Tour + Tulip Farm Visit + Windmill Cruise
Keukenhof is the most beautiful spring garden in the world
$103
per adult
Amsterdam Light Festival Canal Cruise on a Saloon BoatAmsterdam Light Festival Canal Cruise on a Saloon Boat
Seeing the highlights of the Amsterdam Light Festival usually involves a lot of walking—and battling with large crowds
$25
per adult

Light Festival Luxury Heated Saloon Boat CruiseLight Festival Luxury Heated Saloon Boat Cruise
Step aboard a heated, covered saloon boat and admire the Amsterdam Light Festival in cozy comfort. Upgrade by selecting the option that includes unlimited mulled wine, beer, sodas, and snacks.
$37
per adult
Amsterdam Light Festival Canal Cruise (with Drinks Option)Amsterdam Light Festival Canal Cruise (with Drinks Option)
In winter, Amsterdam’s canals host the Amsterdam Light Festival, with surprising, luminous artworks concealed in unexpected places
$34
per adult
Small-Group Guided Sunset Canoe Tour in Waterland with DinnerSmall-Group Guided Sunset Canoe Tour in Waterland with Dinner
This 4 -4
$91
per adult
Art Zoo Museum Admission TicketsArt Zoo Museum Admission Tickets
Secure your entry to one of Amsterdam’s top cultural attractions by booking your admission ticket to the Amsterdam Zoo Museum in advance
$20
per adult

ARTIS: Historical Zoo directly on the old canalARTIS: Historical Zoo directly on the old canal
ARTIS Amsterdam Zoo is located right in the heart of Amsterdam, directly on one of the canals. Discover hundreds of different types of animals, many historic monuments, and beautiful flower gardens.
$36
per adult

3-Hour Mindful Perfume-Making Workshop3-Hour Mindful Perfume-Making Workshop
Join us for a unique experience in Amsterdam. Slow down, reconnect with your senses, and discover the art and science of perfume-making in a small, friendly group.
$148
per adult

National Holocaust Museum Entry TicketNational Holocaust Museum Entry Ticket
Visit the National Holocaust Museum and learn about the persecution of Jews in the Netherlands. The museum is housed in the Hervormde Kweekschool, where hundreds of children were deported and saved.
$24
per adult

Dutch Countryside Sunset Canoe TourDutch Countryside Sunset Canoe Tour
Watch the sunset over the Dutch countryside on a 4-hour canoe tour from Amsterdam. Escape the hustle and bustle of the city center in the evening, and paddle through farms and villages. Stop for a light picnic snack, and swim in a lake on warmer nights.
$92
per adult

take the famous Tulip route tourtake the famous Tulip route tour
Embark on this iconic roadtrip, to see the famous Dutch tulip-fields in all it's glory. Don't miss this colorful, once in a lifetime, experience!
$152
per adult
Mobypark Amsterdam: Parking at Leonardo Royal Hotel AmstelMobypark Amsterdam: Parking at Leonardo Royal Hotel Amstel
Park your worries and your car with confidence in Amsterdam! This parking is safe, secure, and perfect for a long-term stay! This low-price parking is located near the Amstel, Overamstel, and Spaklerweg
$35
per adult
Anne Frank’s Last Walk: VR ExperienceAnne Frank’s Last Walk: VR Experience
Perfect for travelers who couldn’t get tickets to the Anne Frank House, but who want to explore the past of Anne Frank and her story, this Anne Frank’s Last Walk and Experience combines a tour and a VR experience
$51
per adult
Canal Cruise With Virtual RealityCanal Cruise With Virtual Reality
Make your sightseeing experience of Amsterdam even more spectacular during a VR canal cruise that brings culture and history to life
$45
per adult
Book the Arcade Hall in AmsterdamBook the Arcade Hall in Amsterdam
Arcade Hall at UP Events Amsterdam – Classic Games, Modern Vibes, Endless FunStep into the Arcade Hall at UP Events Amsterdam and enter a world of nostalgia, competition, and all-out fun
$24
per adult
Book Laser Tag in AmsterdamBook Laser Tag in Amsterdam
Get ready for heart-pounding excitement with Laser Tag at UP Events Amsterdam – a fast-paced group activity that brings out your inner action hero
$724
per adult
Book a Free Roam VR Experience in AmsterdamBook a Free Roam VR Experience in Amsterdam
Step into the future of gaming with the Free Roam VR Experience at UP Events Amsterdam – a high-intensity, full-immersion adventure using wireless VR headsets
$724
per adult
Book Axe Throwing in AmsterdamBook Axe Throwing in Amsterdam
Ready to unleash your inner Viking? Try Axe Throwing at UP Events Amsterdam – the perfect mix of skill, strength, and pure satisfaction
$48
per adult
Book Bubble Football in AmsterdamBook Bubble Football in Amsterdam
Suit up, bounce hard, and laugh even harder – Bubble Football at UP Events Amsterdam is the ultimate group activity full of action, energy, and epic collisions
$724
per adult
Book Archery in AmsterdamBook Archery in Amsterdam
Archery at UP Events Amsterdam – The Perfect Blend of Skill and ChallengeReady to channel your inner archer? At UP Events Amsterdam, you’ll discover just how satisfying it is to hit the bullseye – again and again
$724
per adult
Your Own Amsterdam. Jordaan: The Atmosphere of Old HollandYour Own Amsterdam. Jordaan: The Atmosphere of Old Holland
Explore the heart of Amsterdam in our tour in Jordaan. Discover hidden courtyards, local shops, and the true spirit of the city, away from tourist crowds.
$171
per adult

Heineken Experience Ticket including 2 DrinksHeineken Experience Ticket including 2 Drinks
Come and discover what lies behind the doors of the former Heineken brewery in Amsterdam, and learn everything there is to know about the world’s favorite beer.
$29
per adult
Dutch Pancakes Cooking Class by the River AmstelDutch Pancakes Cooking Class by the River Amstel
One of the best ways to get to know a place is to try local food, but this small-group Amsterdam cooking tour takes it to the next level
$106
per adult

Zaanse Schans: Wine Tasting with Chateau AmsterdamZaanse Schans: Wine Tasting with Chateau Amsterdam
Enjoy a wine tasting at Café de Slager in Amsterdam with wines from Château Amsterdam. Savor 4 unique wines from the first and largest urban winery in the Netherlands.
$35
per adult
Heineken Experience Amsterdam Ticket With 2 DrinksHeineken Experience Amsterdam Ticket With 2 Drinks
Fans of the Heineken® brand won’t want to miss the Heineken Experience, an attraction conveniently located in central Amsterdam and housed in the first-built Heineken brewery
$29
per adult

French Cooking Class at HomeFrench Cooking Class at Home
Learn to cook a 3-course French meal with a local chef in your own kitchen. Choose from a selection of authentic French recipes to prepare during the class.
$254
per adult
Dutch Pancake Cooking Class and Lunch in an Amsterdam Canal HouseDutch Pancake Cooking Class and Lunch in an Amsterdam Canal House
Learn to make traditional sweet and savory Dutch pancakes in a beautiful canal house on the Amstel river
$77
per adult
Dutch Wine Tasting ExperienceDutch Wine Tasting Experience
Savour the rich flavours of Dutch wines with a tasting experience in Amsterdam. Discover the diverse flavours of Dutch wine, from crisp whites to elegant reds.
$142
per adult
Countryside Bike and Kayak Tour AmsterdamCountryside Bike and Kayak Tour Amsterdam
Leave Amsterdam’s bustle behind and immerse yourself in the tranquil waterways that surround the city on a combined kayaking and biking adventure
$80
per adult
Fabrique des Lumières Entrance TicketFabrique des Lumières Entrance Ticket
Fabrique des Lumières is a popular choice for travelers visiting Amsterdam, but getting a ticket last minute can be tricky
$17
per adult
2-Hour Guided Canoe Trip2-Hour Guided Canoe Trip
Canoe down canals from a small village outside Amsterdam. Learn about the Dutch waterways and see the village and meadows from the canoe.
$45
per adult
Pedal Boat Rental from RijksmuseumPedal Boat Rental from Rijksmuseum
Make your way through Amsterdam's labyrinth of canals at your leisure on a pedal boat! These little white movers let you take in the city and the atmosphere of the canals from a whole new angle
$40
per adult
Amsterdam Pedal Boat RentalAmsterdam Pedal Boat Rental
See Amsterdam as it was meant to be seen, while floating around the city’s charming waterways
$32
per adult
Fabrique des Lumières: The SeaFabrique des Lumières: The Sea
Visit the Fabrique des Lumières in Amsterdam's Westergas park for a unique digital art experience
$21
per adult
Amsterdam Canal Boat Rental - Sail Yourself without a LicenseAmsterdam Canal Boat Rental - Sail Yourself without a License
Rent a canal boat in Amsterdam for a unique self-guided adventure
$113
per adult